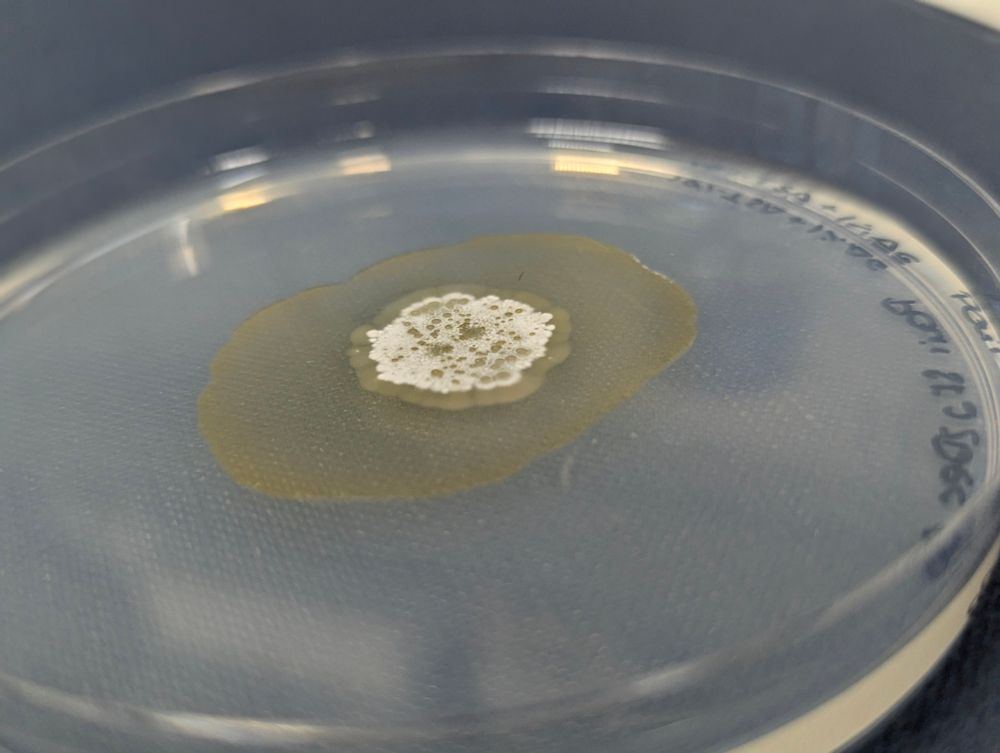

Alejandra Díaz
@alejandradiag.bsky.social
82 followers
77 following
10 posts
From 🇪🇸, PhD student at University of Glasgow🏴 studying Streptomyces spp. interactions in soil🌱🦠. Bioinformatics & Biostatistics MSc University of Barcelona.
https://www.linkedin.com/in/diag-alexandra
Posts
Media
Videos
Starter Packs
Reposted by Alejandra Díaz
Reposted by Alejandra Díaz
Reposted by Alejandra Díaz
Reposted by Alejandra Díaz
Reposted by Alejandra Díaz
Giusy Mariano
@giusym1990.bsky.social
· Apr 4
Giusy Mariano
@giusym1990.bsky.social
· Jan 24
Reposted by Alejandra Díaz
Reposted by Alejandra Díaz
Reposted by Alejandra Díaz
Reposted by Alejandra Díaz
Reposted by Alejandra Díaz
Reposted by Alejandra Díaz
Ákos T Kovács
@evolvedbiofilm.bsky.social
· Mar 22

The effect of combination of root exudates substances on stimulation of Bacillus spores' germination
Root exudates play a crucial role in the rhizosphere by influencing the growth and activity of plant growth-promoting rhizobacteria (PGPR), such as Ba…
www.sciencedirect.com
Alejandra Díaz
@alejandradiag.bsky.social
· Mar 18
Giusy Mariano
@giusym1990.bsky.social
· Jan 24
Reposted by Alejandra Díaz
Reposted by Alejandra Díaz
Reposted by Alejandra Díaz